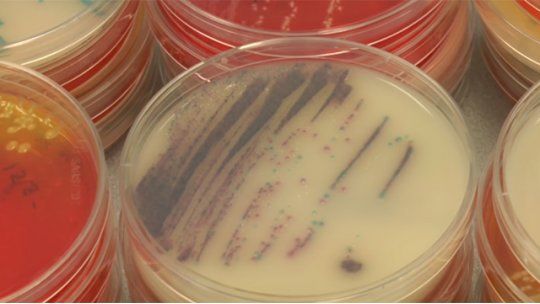
salmonella

La Intendencia de Montevideo anunció que fueron detectados los dos lugares donde se elaboraron los alimentos contaminados con salmonella. Más de 100 personas sufrieron intoxicación alimentaria la semana pasada.
- Nacional >
Detectaron origen de la salmonella que intoxicó a más de 100 personas
Una empresa de catering y una carnicería fueron cerradas momentáneamente hasta que obtenga nueva habilitación.
“Estamos con un seguimiento muy de cerca de las dos empresas que detectamos. Una era empresa de catering cuya producción está discontinuada. Han hecho medidas de desinfección y limpieza pero todavía no le hemos dado el aval para que continúe produciendo”, explicó Marcelo Amado de Regulación Alimentaria de la Intendencia de Montevide.
“Se detectó que algunos alimentos estaban contaminados, sobre todos las milanesas de fiambre y queso; en eso se detectó salmonella”.
“Ayer tuvimos una reunión con la gente de INAC quienes tomaron las medidas en la carnicería. Se les descontinuó la producción y se están reviendo algunas prácticas porque esa carnicería no estaba bien adecuada para algunos alimentos”.
Lo más visto
video
PROCESO JUDICIAL
Condenan a 12 años de cárcel a Moisés Martínez, el joven de 28 años que mató a su padre tras años de abuso
LA DEFENSA APELARÁ EL FALLO
Hermana de Moisés: "Hoy lo condenan a 12 años por llevar la sangre de él y un padre que abusa deja de ser tu padre"
FLOR DE MAROÑAS
"Hace años que pedimos ayuda para cortar y sacar el árbol", dice la hija de la mujer herida por caída de una rama
ESTADO DEL TIEMPO
Nubel Cisneros llamó a "no descuidarse porque todavía los vientos siguen bastante fuertes" y anunció bajas temperaturas
Punta de rieles
Dejá tu comentario